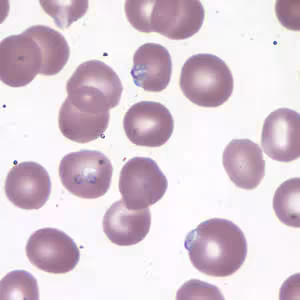

Case #177 – April, 2006
A 43-year-old man went to his physician complaining of fatigue. The man reported that he hiked and camped a lot throughout the northeastern United States weeks before the symptoms started. He also reported traveling to Kenya for vacation a month before his doctor’s visit and stated that he had complied with the recommended malaria prophylaxis regimen. A blood examination was ordered, and a thick and thin blood film were made and stained with Giemsa. Figure A shows what was seen on the thick blood film, and Figure B shows the thin blood film. What is your diagnosis? Based on what criteria?

Figure A
Figure B
Images presented in the DPDx case studies are from specimens submitted for diagnosis or archiving. On rare occasions, clinical histories given may be partly fictitious.
DPDx is an educational resource designed for health professionals and laboratory scientists. For an overview including prevention, control, and treatment visit www.cdc.gov/parasites/.
